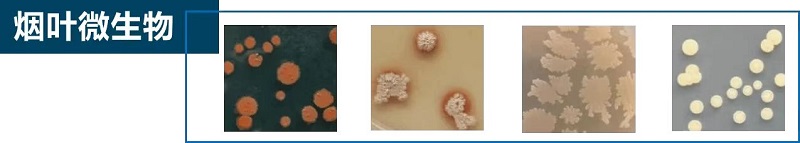

前瞻性烟用香精香料解决方案
我们长期致力于开发可显著改善卷烟抽吸舒适感和独特香味体验感的烟用香精香料产品,提供既符合国际通用标准,又符合不同国家/地区标准及法规要求的产品,确保安全性与全球性多区域市场准入,以满足对产品有严格要求的国内或国际客户的需求。
同时,经过长期的技术积累,我们在烟用香精香料领域开创了前瞻性创新理论,并拥有多项特色化核心技术:

通过系统研究人脑认知中枢对吸烟过程中香味的综合感知机制,云南瑞升烟草技术开创了卷烟香味风格定向设计理论,并在此之上发展出烟用香精香料研发新范式。该理论通过解析嗅觉-味觉感知区域及其关联区域的协同激活机制,精准定位可调控感官体验的功能组分,为开发高辨识度香韵提供科学依据,并指导探索相关全新物质组分进行香精的组方调配。
基于此理论,我们开展了创新性的研发实践:
• 持续寻找并发现全新的天然香味物质组分/香原料;
• 持续开发全新的烟用调香技术及产品。
这类新型烟用香精香料有效扩展并提升了传统产品的功能及效用,通过产生协同效应,使香味体验得到拓展、丰富,产生具吸引力的香气香韵特性,可赋能国内外客户及其产品有效提升市场竞争力。

特色化核心技术
在烟用香精香料领域,我们拥有多项特色化核心技术:
1. 集成化绿色精准提取系统技术
为了得到天然原料中的关键致香成分,我们联用并集成绿色萃取技术,包括:
• 超临界CO₂萃取;
• 亚临界萃取;
• 微波与超声波辅助提取;
• 分子蒸馏及色谱分离。
现已建立多种植物资源的集成化绿色精准提取系统技术,实现了关键香味组分的充分富集与定向分离。相较于传统技术,该技术制备的天然香料产品具备纯度高、保质期长、安全性好的显著特征。在高效、降本、环保、安全性、功能化开发与应用等方面实现了技术突破,全面构建基于绿色发展需要的技术体系。




2. 生物创香提质技术
通过广泛收集、分离、筛选并鉴定特色原料(如优质鲜花、野生菌、烟草及香料植物)中的功能微生物,我们系统建立并持续扩充与优化功能性微生物菌种资源库。通过在再造烟叶、烟草原料(梗丝、低次烟叶、复烤烟叶)及功能性香料等方向开展生物技术深度应用研究与产品研发,云南瑞升烟草技术系统地开发了兼具普适性与靶向性的生物创香提质技术及其系列产品,构建了瑞升特色生物技术在烟用香料领域的开发及应用体系。

3. 天然关键致香组分结构化重组技术
我们通过对天然香原料中的关键致香组分进行定位切割与精准分离,实现了目标香气化合物及其风味前体的高选择性富集。在此基础上,我们运用结构化重组技术,立体地定向重构特色香韵,构建了感官特性更丰富、层次更分明的香精体系。该技术有效提升了天然香韵的丰厚度与透发性,并基于科学洞察与分析,设计出具有高辨识度与品牌彰显度的特色香韵风格。
